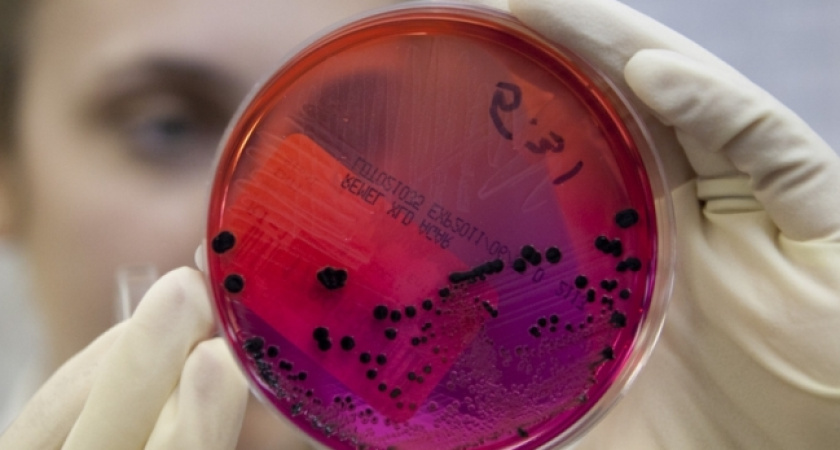
Воронежской области вновь угрожает вирус АЧС

Воронежской области вновь угрожает вирус АЧС
- 18 августа 2015
- Редакция
Разработан план по организации дополнительных мер безопасности
Воронежская область оказалась в «вирусной осаде». Вспышки африканской чумы свиней уже зарегистрированы в трех соседних областях - Курской, Саратовской и Волгоградской.
На заседании областного оперативного штабабыл разработан план работы по усилению санитарной безопасности. Теперь к постоянно действующим на территории региона семи ветеринарно-полицейским постам добавился ещё один - в селе Третьяки Борисоглебского района, на границе с Саратовской областью.
Кроме того, на всех постах объявлен усиленный режим работы. Круглосуточно ведется досмотр автомобилей на предмет провоза живых свиней, животноводческой продукции и кормов.
Отмечается, что ежедневно на постах ветеринарами и сотрудниками ГИБДД досматривается более тысячи единиц автотранспорта, перевозящего подконтрольные госветнадзору грузы.
В целях безопасности главам местных администраций поручено взять под личный контроль переучет всех свиней в животноводческих и личных подсобных хозяйствах, а также принять усиленные меры профилактики заразы.